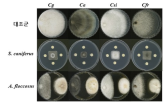
과수,탄저병,발견

지난 주요뉴스 한국경제TV에서 선정한 지난 주요뉴스 뉴스썸 한국경제TV 웹사이트에서 접속자들이 많이 본 뉴스 한국경제TV 기사만 onoff
-
[이지 사이언스] 우주서 본 한반도 가뭄…북한 농업 타격 더 컸다 2025-10-18 08:00:04
작물의 색이나 자란 면적 등을 분석해 생육 정도나 피해를 조기에 감지할 수 있고, 북한과 같은 접근이 어려운 국가의 데이터도 간접 분석할 수 있기 때문이다. 연구팀은 비슷한 기후와 지리를 공유하면서도 한쪽은 식량 위기를 겪지만, 다른 한쪽은 기후 재해로 인한 작물 피해가 적은 한반도에 주목해 강수량이 평년 절반...
- 뉴스 > 경제
- 바로가기

-
카자흐스탄 돼지고기 중국 수출길 열려…양국 통관협정 체결 2025-10-17 15:57:39
작물 파종단계에서 수확물에 대해 선물(future) 구매를 할 수 있다. 사파로프 장관은 자국이 중국에 연간 300만∼400만t의 곡물 및 사료를 수출할 수 있다고 말했다. 카자흐스탄 농업부에 따르면 올해 들어 7월까지 양국 간 농산물 무역액은 9억9천230만달러(약 1조4천억원)로, 지난해 동기 대비 28%나 급증했다. 지난해...
- 뉴스 > 정치
- 바로가기

-
낙동강생물자원관, 과수 탄저병 막는 담수 미생물 발견 2025-10-16 06:00:09
사는 균류를 확보하고 이를 활용해 작물 보호제를 만드는 연구를 진행해왔다. 최근 안양천 등에서 연구진이 발견한 아스퍼질러스 플로코수스와 스트렙토마이세스 카니퍼루스라는 균주는 과수 탄저병을 일으키는 병원균의 균사생장을 70% 이상 억제했다. 특히 이 균주들은 고추 모종에 투입했을 때 줄기 길이와 굵기를 약...
- 뉴스 > 경제
- 바로가기
-
샤인머스캣 명성 이을 신품종 3총사 '코코볼·슈팅스타·홍주씨들리스' 2025-10-15 15:33:51
현장 실증을, 한국포도수출연합은 홍보와 수출 기반을 맡고 있다. 내년에는 홍콩·베트남 등 아시아 시장을 중심으로 품종별 1톤 규모의 시범 수출을 추진한다. 김대현 농진청 국립원예특작과학원 원예작물부장은 "세 가지 신품종은 소비자 기호에 맞으면서도 농가 소득 안정에 기여할 수 있다"며 "전문 생산단지 구축으로...
- 뉴스 > 경제
- 바로가기

-
AI+바이오 강국에 대한 유감[정삼기의 경영프리즘] 2025-10-15 11:41:57
작물 수확량 증대, 영양 개선, 해충과 질병, 가혹한 환경에서도 살아남는 유전자 변형 작물, 식품의 맛과 유통기한 개선, 질병 퇴치용 가축용 백신에 관여됩니다. 이외에도 바이오 기술은 오염된 토양과 물을 정화하고 폐기물을 처리하는 데에도 등장합니다. 이처럼 바이오는 적용 범위가 상상을 초월합니다. 따라서 지난...
- 뉴스 > 경제
- 바로가기

-
송미령 농식품장관 "내년에 쌀 수급 안정 추가 대책"(종합) 2025-10-14 21:53:26
것"이라고 말했다. 그는 유전자변형작물(LMO) 면화씨가 서울 경동시장에서 약재로 불법 유통된 데 대해서는 "농림축산용, 산업용 LMO가 용도 외로 유통되는 일이 없도록 철저히 관리하겠다"고 밝혔다. 이날 정부의 농축산물 할인 지원이 대형 유통업체의 배만 불리며 농가에는 도움이 되지 않는다는 지적도 나왔다. 이에 송...
- 뉴스 > 경제
- 바로가기

-
당뇨·고혈압 예방 '잡곡 혼합비율' 경제성 커…농진청, 산업화 추진 2025-10-14 15:04:40
증가해 경제적 가치가 더 확대할 것으로 농진청은 내다보고 있다. 하태정 농진청 품질관리평가과장은 "이번 분석 결과를 바탕으로 잡곡밥 취반 특성 연구와 질환별 맞춤 잡곡 혼합 기술 개발을 이어갈 계획"이라며 "국산 식량작물이 돌봄식(케어푸드) 등 산업 소재로 활용되면서 소비 확대와 농가 소득 증대에도 크게...
- 뉴스 > 경제
- 바로가기
-
필터 교체 없는 지하수 여과기…농진원-전남대, 실증 성공 2025-10-13 15:35:04
이물질로 인해 펌프와 분사기 고장이 발생하거나, 작물 표면 손상 및 축산농가의 가축 질병 등으로 이어지는 사례가 이어지면서 피해가 커지고 있다. 홍세운 전남대 교수 연구팀이 개발한 듀얼사이클론 여과기는 두 개의 사이클론을 반대 방향으로 회전시켜 물과 이물질을 신속하게 분리하는 원리를 적용했다. ...
- 뉴스 > 경제
- 바로가기
-
"지난해 가루쌀 소비량, 생산량의 13% 그쳐…논콩도 재고 폭증" 2025-10-13 08:43:50
늘어날 것으로 전망됐다. 전략작물직불제와 벼 재배면적 조정제 등 정부 정책에 따라 재배 면적이 크게 늘었다. 하지만 수입 콩보다 가격이 몇 배 비싸 판매처를 찾기 어려워 과잉생산이 우려되는 상황이다. 정부가 지난 2023년 쌀 수급 안정 등을 이유로 가루쌀·논콩 모두 전략작물직불제 품목에 추가하면서 재배를...
- 뉴스 > 경제
- 바로가기

-
"마늘·양파·보리도 농업수입안정보험 가입하세요" 2025-10-12 11:00:00
농작물재해보험의 보장 범위인 자연재해·화재·병충해 등에 따른 피해에 더해 시장가격 하락에 따른 농가의 경제적 손실도 보상하는 제도이다. 농가의 품목별 수입(보험 가입 연도)이 과거 평균 수입의 일정 수준 미만으로 줄어들 때 감소분 전액을 보상해준다. 올해 농업수입안정보험은 15개 품목이 대상이다. 콩, 마늘,...
- 뉴스 > 경제
- 바로가기







